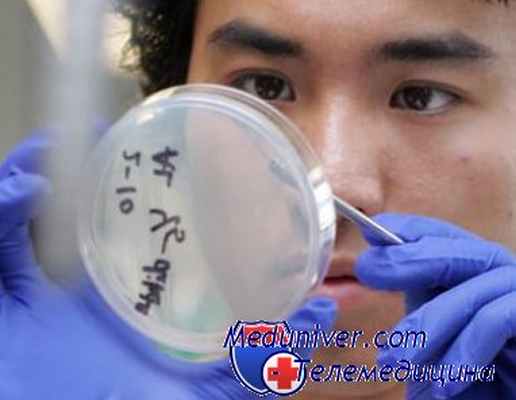
кишечная непроходимость

Распространенность кишечной непроходимости. Кишечные инфекции и непроходимость
Добавил пользователь Владимир З. Обновлено: 06.01.2026
Кишечная непроходимость скорее — это нарушение пассажа кишечного содержимого, которое вызывается сдавлением, спазмом, нарушением иннервации или обтурацией просвета кишечника.
Кишечную непроходимость скорее относят к симптомам, а не самостоятельному заболеванию.
Кишечная непроходимость может быть связана с инородными телами, опухолями кишечника, глистными инвазиями, спинномозговой травмой, тромбозами и тд.
Существует непроходимость как толстого, так и тонкого кишечника. Также может быть полная кишечная непроходимость (у человека нет стула и не отходят газы на протяжении длительного времени) и частичная (характеризуется диареями).
Кишечная непроходимость относиться к числу наиболее сложных патологий и чаще всего встречается в возрасте от 30 до 60 лет. При чем, у мужчин данная проблема встречается чаще, чем у женщин. Если человеку с острой кишечной непроходимостью не оказать помощь в течении 4–6 часов, то риск гибели доходит до 90%.
Что происходит в организме?
Кишечная непроходимость может быть механическая (обтурационная, странгуляционная и смешанная), сосудистая (связана с инфарктом кишечника), динамическая (спастическая и паралитическая). По уровню расположения препятствия для продвижения пищевых масс выделяют высокую и низкую тонкокишечную непроходимость, и толстокишечную непроходимость. При низкокишечной непроходимости может быть задержка стула и газов, при высокой непроходимости — некоторое время стул присутствует.
Динамическая непроходимость может вызываться травмой, перитонитом, отсутствием двигательной активности. Механическая непроходимость может быть связана с онкологическим заболеванием, перекрутом кишечника, спайками. Вне зависимости от причины и вида кишечной непроходимости, симптомы у пациента, как правило, схожи — тошнота, рвота (достаточно часто с неприятным запахом кала), вздутие живота, задержка стула, схваткообразные боли, общее недомогание.
Кишечная непроходимость это полиэтиологический синдром и своевременная диагностика и лечение являются решающими в исходе такого достаточно тяжелого состояния.
Причины и факторы риска возникновения заболевания
- Спаечный процесс в брюшной полости
- Опухолевой процесс, приводящий к обтурации просвета кишечника. При чем процесс может быть как доброкачественный, так и злокачественный
- Грыжи передней брюшной стенки
- Особенности анатомического строения кишечника — подвижная слепая кишка, удлинённая сигмовидная кишка и др.
- Сдавление кишечника близлежащей опухолью
- Дивертикулит
- Инфекции
- Желчекаменная болезнь
- Перекрут части кишечника
- инородное тело (при проглатывании)
- Гипотиреоз
- Сахарный диабет
- Отравление солями тяжелых металлов, никотином
- Болезнь Паркинсона
- Почечная колика
- Острый инфаркт миокарда
- Тромбозы брыжеечных артерий
- Болезнь Гиршпрунга
- Нарушение питания
- Расстройство моторной функции кишечника
- Длительные запоры
- Травмы позвоночника
- Инсульт
Как проявляется заболевание. Симптомы
При данной патологии наблюдаются следующие симптомы:
- Бледность кожных покровов
- Боль в животе
- Вздутие живота
- Запор
- Рвота
- Тахикардия
- Асимметрия живота
Если Вы наблюдаете какие-либо симптомы — во избежании осложнений не занимайтесь самолечением и обратитесь к врачу
Болею ли я даным заболеванием?
Для того, чтобы определить, болеете ли вы данным заболеванием:
Сверьте Ваши симптомы с теми, которые в списке
Если Вы обнаружили какие-либо из симптомов, то:
Пройдите доврачебный скрининг. Он поможет иденцифицировать диагноз в кратчайшие сроки, при этом сэкономив ваше время и средства
Мы поможем вам корректно интерпретировать результаты лабораторных исследований на нашем сервисе
Запишитесь к врачу. Он поможет установить диагноз и, при необходимости, назначит лечение
Так же Вы можете пройти дополнительные методы исследования для подтверждения/опровержения диагноза
Доврачебный скриннинг
Доврачебный скрининг помогает врачу в постановке предварительного диагноза, экономит время и сокращает количество визитов к специалисту.
Лабораторная диагностика
- Общий анализ крови + лейкоцитарная формула + СОЭ
- Общий анализ мочи
- Биохимический анализ крови (общий белок, билирубин, мочевина, креатинин, глюкоза, АСТ, АЛТ, ЛДГ, амилаза, натрий, калий, хлор, СRP)
Инструментальная и функциональная диагностика
Хотите расшифровать заказанные анализы?
Мы расшифруем и интерпретируем результаты лабораторных анализов
Врачи, которые лечат данную патологию
Специалисты, которые помогут установить диагноз и, при необходимости, назначить лечение
К сожалению, на нашей платформе не размещены профильные специалисты из вашего города.
Если вы врач или эксперт в этой области медицины и хотите разместиться в этом месте, то напишите нам.
Дополнительные методы исследования
Методы исследования, которые может дополнительно назначить вам врач
Лабораторная диагностика
- Коагулограмма
- Копрограмма
- Анализ кала на скрытую кровь
- Определение уровня онкомаркеров
Инструментальная и функциональная диагностика
- Ректороманоскопия
- МРТ
- Ирригоскопия
- Рентгенография брюшной полости
- Колоноскопия
Лечение
Хирургическое лечение:
- При подозрении на кишечную непроходимость необходимо как можно скорее обратиться к хирургу. Самолечение категорически противопоказано!
Если лечение подобрано верно, то:
- Нормализуется стул
- Исчезает тошнота, рвота
- Улучшается общее самочувствие
- Проходят боли в животе
Возможно, вы сомневаетесь в поставленном диагнозе и корректности назначенного лечения, вас обследовали не в полном объеме. Вы можете обратиться за вторым мнением к другому специалисту.
Риски для здоровья и возможные последствия (что будет, если я не буду лечить или корректировать лечение)
- Нарушение механизма опорожнения кишечника
- Общая интоксикация организма
- Болевой шок
- Поносы
- Перфорация кишечной стенки
- Запоры
- Некротизация участка
- Сепсис
- Несостоятельность кишечного анастамоза (после операции)
- Спаечный процесс в брюшной полости
- Парез кишечника
- Перитонит
Как не заболеть? Профилактика
- Нормализация питания (побольше кисломолочных продуктов, Овощей, фруктов, цельнозерновых продуктов)
- Снижение массы тела
- Профилактика запоров
- Своевременное лечение заболеваний ЖКТ
- Постараться ограничивать действие стрессора
- Предупреждение развития спаечной болезни
- Отказ от вредных привычек
- Устранение глистной инвазии
- Достаточная физическая активность
Заболевания, при которых могут быть схожие симптомы
- Парапроктит
- Рак прямой кишки
- Геморрой
- Стенокардия
- Острый аппендицит
- Почечная колика
- Панкреатит
- Абсцесс брюшной полости
- Инфаркт миокарда
- Сигмоидит
- Язвенный колит
- Болезнь Крона
- Перитонит
Интересные факты о заболевании
- Около 5% хирургических пациентов с экстренной госпитализацией поступают с диагнозом кишечная непроходимость
- Чаще всего прибегают к хирургическому лечению, но иногда пациентов могут лечить консервативно
- При хирургическом лечении происходит резекция некротизированного участка
- Иногда кишечная непроходимость может быть связана с заболеваниями нервной системы (психические заболевания, ЧМТ, спинномозговые травмы и тд.)
- Чем раньше диагностирована кишечная непроходимость — тем лучше прогноз
- Клубок аскарид (глисты) могут закупоривать просвет кишечника и вызывать кишечную непроходимость
- При низком уровне калия может быть кишечная непроходимость: миоциты (мышечные клетки) теряют способность нормально сокращаться, уменьшается частота и амплитуда перистальтических сокращений, что может привести к кишечной непроходимости
- Кишечную непроходимость может вызвать отравление тяжелыми металлами
- Каловые камни и копролиты могут вызывать кишечную непроходимость
- При злокачественном процессе иногда в ходе операции приходиться формировать колостому на передней брюшной стенке
Информация, представленная на сайте, носит исключительно информационный характер. При возникновении симптомов какого-либо заболевания необходимо обратиться к врачу.
Авторы статей
Источники информации
Мы создали платформу телемедицинских сервисов для решения практических и информационных медицинских проблем доступным и понятным способом.
Распространенность кишечной непроходимости. Кишечные инфекции и непроходимость
Распространенность кишечной непроходимости. Кишечные инфекции и непроходимость
Одним из характерных симптомов кишечной непроходимости является метеоризм. Вздутие живота в эпигастральной области характерно для непроходимости в верхнем отделе тонкой кишки, а равномерное вздутие живота — для непроходимости нижних отделов кишечника. При завороте сигмовидной кишки наблюдается "косой живот", при котором выявляется асимметрия живота, располагающаяся в направлении от правого подреберья через пупок в направлении левой подвздошной области.
Более равномерное вздутие живота наблюдается при обтурационной кишечной, а неравномерное — при странгуляционной непроходимости. Одним из ранних симптомов кишечной непроходимости является симптом Валя (через переднюю брюшную стенку контурируется раздутая петля кишки), а очень важным — видимая перистальтика кишок, а также "шум плеска" при легком сотрясении брюшной стенки.
Кишечные шумы выслушиваются при аускультации брюшной полости только в начале заболевания, а затем прекращаются.
Изменения крови в первом периоде болезни отсутствуют. При учащении рвоты отмечаются сгущение крови и увеличение показателя гематокрита, числа эритроцитов и лейкоцитов. С развитием перитонита доминирует нейрофильный лейкоцитоз. Во 2—3-м периодах заболевания набюдаются олигоанурии и увеличение концентрации мочевины и креатинина в сыворотке крови.
Диагноз кишечной непроходимости должен подтверждаться характерной рентгенологической картиной — появлением чаш Клойбера с горизонтальными уровнями жидкости и газа, которые могут располагаться в виде арок на обзорных рентгенограммах брюшной полости. Необходимо отметить, что при пищевых токсикоинфекциях в кишечнике может быть много газа, но он располагается беспорядочно вдоль всей кишки. При этом отсутствуют четкие контуры характерные для непроходимости. '
В последние годы в диагностике кишечной непроходимости приобретает большое значение метод лапароскопии.
В хирургическое отделение нашей больницы в 60-е годы было госпитализировано 238 больных с острой кишечной непроходимостью. Все они были направлены в стационар с диагнозом острой кишечной инфекции, который не подтвердился при обследовании. Странгуляционная кишечная непроходимость была выявлена у 74,8 % больных, обтурационная непроходимость опухолевого генеза — у 3,3 %, инвагинации — у 5,6 %, завороты тонкой и толстой кишки — у ]6 % и узлообразование — у 0,4 % больных.
Сложность дифференциальной диагностики кишечной непроходимости и острых кишечных инфекций несомненна. Диагностические ошибки часто связаны с недооценкой внезапности появления боли в области живота, ее интенсивностью и характером. Максимальное внимание должно быть уделено пациентам, в анамнезе которых есть указания на различные оперативные вмешательства на органах брюшной полости, когда существует угроза странгуляционной кишечной непроходимости.
За 20 лет наблюдений больных с острыми кишечными инфекциями нами было выявлено у 357 больных с четкой клинической картиной пищевых токсикоинфекций (сальмонеллезов) развитие странгуляционной кишечной непроходимости. У 57,9 % больных после перенесенной в прошлом операции на брюшной полости периодически отмечалась боль в области живота (10,6 % из них ранее госпитализировались в хирургические стационары по поводу спаечной болезни брюшной полости).
Клинические признаки спаечной кишечной непроходимости развивались на 3-й день заболевания у 39,8 % больных, на 4—5-й — у 49,9 % больных. Лишь у немногих пациентов (2,5 %) симптомы спаечной кишечной непроходимости появились на 2-й день пищевой токсикоинфекций или позже 5-го дня (7,8 %). Причинами странгуляционной кишечной непроходимости у больных с пищевыми токсикоинфекциями, в анамнезе у которых ранее была спаечная болезнь, послужили изменения моторной функции кишечника с преобладанием спазма его мускулатуры [Стручков В.И., Луцевич Э.В., 1986]. У 66 больных (18,5%) странгуляционная непроходимость была выявлена в начальной стадии заболевания, у 286 (80,1 %) — в разгар болезни и у 5 больных (1,4 %) — в период реконвалесценции острой кишечной инфекции. Все пациенты, у которых развилась спаечная кишечная непроходимость, были переведены в хирургический стационар.
Информация на сайте подлежит консультации лечащим врачом и не заменяет очной консультации с ним.
См. подробнее в пользовательском соглашении.
Распространенность кишечной непроходимости. Кишечные инфекции и непроходимость
- длительное голодание с последующим обильным переполнением кишечника грубой пищей;
- операции на органах брюшной полости и малого таза;
- грыжи передней брюшной стенки.
Б. Объективный осмотр больного
Тяжесть состояния пациента обусловлена формой, уровнем и временем, прошедшим от дебюта ОКН.
Язык при выраженной клинической картине сухой, покрыт коричневым или желтым налетом.
В терминальных стадиях заболевания появляются трещины слизистой оболочки, афты, что указывает на тяжелую интоксикацию, обезвоживание и наличие перитонита.
2. Объективный осмотр живота [1, 4, 7, 8]. При подозрении на ОКН необходимо обследование всех возможных зон формирования грыж, для исключения их ущемления. Ущемление участка кишки без брыжейки в узких грыжевых воротах, как правило, не сопровождается выраженными болевыми ощущениями [2, 3].
а) Ad oculus. Вздутие живота - один из характерных признаков ОКН. Степень выраженности этого симптома бывает разной и, как правило, увеличивается по мере увеличения сроков заболевания. Равномерное увеличение живота обычно характерно для пареза кишечника и низких форм толстокишечной непроходимости. При высокой непроходимости живот увеличен в верхнем отделе, при завороте обычно заметно срединное выпячивание, при инвагинатах асимметрия чаще бывает в правой подвздошной области. В поздние сроки при возникновении недостаточности илеоцекального клапана (баугиниевой заслонки) живот становится симметрично вздутым. При заворотах сигмовидной кишки отмечается вздутие верхних отделов правой или левой половины живота, и тогда живот принимает характерный «перекошенный» вид.
Иногда во время болевой схватки контурируется раздутая кишечная петля с волнами перистальтики и урчанием. Особенно выраженным симптом «видимой перистальтики» бывает при подострых и хронических формах обтурационной непроходимости, при которой успевает развиться гипертрофия мышечного слоя приводящего отдела кишечника. При этом перистальтическую волну у худых больных с атоничной брюшной стенкой можно проследить до уровня обтурации.
При странгуляционной непроходимости иногда отмечается симптом Чугуева: больной лежит на спине с согнутыми в коленных суставах и подтянутыми к животу нижними конечностями, на животе видна глубокая поперечная полоса.
б) Поверхностная пальпация живота. Брюшная стенка при поверхностной пальпации обычно мягкая, безболезненная.
в) Глубокая пальпация. Иногда можно обнаружить наибольшую болезненность в месте расположения кишечных петель, подвергшихся странгуляции. У ряда больных удается прощупать фиксированную и растянутую в виде баллона петлю кишки (симптом Валя), при перкуссии над которой слышен тимпанический звук с металлическим оттенком (положительный симптом Кивуля). В поздние сроки заболевания при сильном растяжении кишечника определяется характерная ригидность брюшной стенки (положительный симптом Мондора), которая при пальпации напоминает консистенцию надутого мяча.
При инвагинации может наблюдаться симптом Бабука: если в промывных водах крови нет, живот пальпируют в течение 5 мин и после повторной сифонной клизмы вода может иметь цвет мясных помоев.
В случае илеоцекальной инвагинации в связи с перемещением инвагинированного отрезка кишечника правая подвздошная ямка при пальпации бывает пустой (симптом Шимона-Данса).
г) Перкуссия. Над растянутыми кишечными петлями определяют высокий тимпанит. Одновременно с этим над растянутыми кишечными петлями слышен «шум плеска» (симптом Склярова), что свидетельствует о скоплении в приводящей петле жидкости и газа.
д) Аускультация живота. Перистальтические шумы в первые часы заболевания усилены, нередко слышны на расстоянии. При аускультации можно определить усиленную перистальтику (урчание, переливание, бульканье, «шум падающей капли» - симптом Спасокукотского, «шум лопнувшего пузыря» - симптом Вильса). Бурная перистальтика более характерна для обтурации. При странгуляции усиление перистальтических шумов наблюдают в начале заболевания. В дальнейшем вследствие некроза кишки и перитонита перистальтические шумы ослабевают и исчезают (симптом «гробовой тишины»), при аускультации живота хорошо слышны дыхательные и сердечные шумы (положительный симптом Латейссена).
е) Per rectum. Иногда можно определить причину непроходимости (опухоль, каловый камень, инородное тело), а при инвагинации - кровь или кровянистое содержимое. Часто можно пропальпировать раздутую петлю тонкой кишки (симптом Гольда), нависание стенок кишки, служащих признаком скопления жидкости в малом тазу. При завороте и узлообразовании сигмовидной кишки ампула прямой кишки пустая, анус зияет (симптом Грекова, или симптом Обуховской больницы). Для этой патологии характерен также симптом Цеге-Мантейфеля: в прямую кишку удается ввести не более 300-500 мл жидкости.
В. Инструментальные исследования
1. Рентгенологическое обследование является основным специальным методом диагностики ОКН. Обзорная рентгенография брюшной полости должна проводиться при малейшем подозрении на ОКН. При этом выявляется ряд признаков. В норме газ имеется в ободочной кишке. Появление газа в тонкой кишке указывает на непроходимость. Характер скопления газа в просвете кишечника различается при разных вариантах КН (рис. 1). Рисунок 1. Схема скопления газа в просвете кишечника при разных вариантах КН. а - высокая тонкокишечная непроходимость. Возможно наличие единичных горизонтальных уровней жидкости и газа. Наличие газа в толстой кишке не характерно Рисунок 1. Схема скопления газа в просвете кишечника при разных вариантах КН. б - низкая тонкокишечная непроходимость. Обычно видны множественные горизонтальные уровни жидкости и газа (чаши Клойберга). Наличие газа в толстой кишке не характерно Рисунок 1. Схема скопления газа в просвете кишечника при разных вариантах КН. в - странгуляционная кишечная непроходимость. Могут быть как единичные, так и множественные горизонтальные уровни жидкости и газа. Наличие газа в толстой кишке не характерно. Обычно по снимкам удается определить, петли какой кишки - тонкой, толстой или обеих - растянуты газом. При наличии газа в тонкой кишке хорошо видны спиралевидные складки слизистой оболочки (Керкринговы складки), занимающие весь поперечник кишки.
В тощей кишке они имеют вид круговой ребристости, напоминающей «скелет селедки» (симптом Кейcи), в подвздошной кишке - более редкие, прямые и толстые. При скоплении газа в толстой кишке видны гаустры, которые занимают лишь часть поперечника кишки [7, 9-12].
В более ранних стадиях КН рентгенологически может определяться скопление газа (без уровня жидкости) в петле кишки соответственно определяемому клинически симптому Валя (симптом Гинтце). На соответствие растянутой и напряженной петле кишки зоны скопления газа в виде арки указывает симптом Штирлина.
При механической тонкокишечной непроходимости в толстой кишке газа немного или нет. При толстокишечной непроходимости и сохранной функции илеоцекального клапана отмечают значительное вздутие толстой кишки, в тонкой кишке газ может отсутствовать. Недостаточность илеоцекального клапана приводит к растяжению как тонкой, так и толстой кишки.

На рентгенограммах, полученных в положении стоя или лежа на боку, обычно видны горизонтальные уровни жидкости и газа (рис. 2). Рисунок 2. Обзорная рентгенограмма брюшной полости. Видны чаши Клойбера, уровни жидкости. Заполненные газом кишечные петли имеют вид опрокинутых чаш (чаши Клойбера). Они появляются при странгуляции через 1-2 ч после начала заболевания, при обтурации - через 3-5 ч. По размерам чаш Клойбера, их форме и локализации можно судить об уровне непроходимости.
При тонкокишечной непроходимости чаши Клойбера небольших размеров, ширина горизонтального уровня жидкости больше, чем высота столба газа над ним. Обычно наблюдается большое количество горизонтальных уровней с изменением их расположения в течение времени и перемещением жидкости из одной петли в другую. Горизонтальные уровни жидкости ровные. На фоне газа хорошо видны складки слизистой оболочки (складки Керкринга), принимающие форму растянутой спирали.
При непроходимости тощей кишки горизонтальные уровни жидкости локализуются в левом подреберье и эпигастральной области. При непроходимости в терминальном отделе подвздошной кишки уровни жидкости расположены в области мезогастрия.
При тонкокишечной непроходимости, кроме чаш Клойбера, на рентгенограммах видны растянутые газом кишечные петли, принимающие форму «аркад» или «органных труб», похожих на перевернутые буквы J и U.
При толстокишечной непроходимости горизонтальные уровни жидкости расположены по периферии брюшной полости, в боковых отделах живота, и их меньше, чем при тонкокишечной непроходимости. Высота чаш Клойбера преобладает над шириной. На фоне газа видны полулунные складки слизистой оболочки («гаустры»). Уровни жидкости не имеют ровной поверхности («зеркала»), что обусловлено наличием в толстой кишке плотных кусочков кала, плавающих на поверхности жидкого кишечного содержимого.
При динамической паралитической непроходимости, в отличие от механической, горизонтальные уровни жидкости наблюдаются одновременно как в тонкой, так и в ободочной кишке. Перемещения кишечных уровней со временем из одного колена кишки в другое не наблюдается. При динамической спастической непроходимости по ходу тонкой кишки видны мелкие чаши Клойбера, расположенные цепочкой слева сверху вниз и вправо.

Отличить паралитическую непроходимость кишечника от механической тонкокишечной непроходимости с помощью обзорной рентгеноскопии бывает довольно сложно (см. таблицу). Рентгеноконтрастное исследование применяется с целью дифференциальной диагностики КН в сложных случаях [2, 7, 10, 13]. Вариант введения контраста зависит от предполагаемого уровня окклюзии кишечника. Так, бариевую взвесь внутрь дают при признаках высокой обтурационной непроходимости и с помощью клизм вводят при симптомах низкой непроходимости. При необходимости динамического исследования пассажа бария внутрь назначают рентгеноконтрастный препарат, при задержке которого более 6 ч в желудке и 12 ч в тонкой кишке диагностируется нарушение проходимости или двигательной активности кишечника. При механической непроходимости контрастная масса ниже препятствия не поступает.
Таким образом, показаниями к проведению рентгеноконтрастного исследования при ОКН служат:
- подтверждение или исключение КН;
- сомнительные случаи, при подозрении на кишечную непроходимость с целью дифференциальной диагностики и при комплексном лечении;
- спаечная ОКН у больных, неоднократно подвергшихся оперативным вмешательствам, при купировании последней;
- любая форма тонкокишечной непроходимости (за исключением странгуляционной), когда в результате активных консервативных мероприятий на ранних этапах процесса удается добиться видимого улучшения. В данном случае возникает необходимость объективного подтверждения правомерности консервативной тактики. Основанием для прекращения мониторинга рентгенологического исследования является фиксация поступления контраста в толстую кишку;
- диагностика ранней послеоперационной непроходимости у больных, перенесших резекцию желудка. Отсутствие пилорического жома обусловливает беспрепятственное поступление контраста в тонкую кишку. В этом случае выявление феномена стоп-контраста в отводящей петле служит показанием к ранней релапаротомии.
Условия проведения исследований с контрастным веществом при ОКН:
1) рентгеноконтрастное исследование для диагностики ОКН можно использовать лишь при полной убежденности (на основании клинических данных и результатов обзорной рентгенографии брюшной полости) в отсутствии странгуляционной формы непроходимости, составляющей угрозу быстрой утраты жизнеспособности ущемленной петли кишки;
2) динамическое наблюдение за продвижением контрастной массы необходимо сочетать с клиническим наблюдением, в ходе которого фиксируются изменения местных физикальных данных и общего состояния больного. В случае усугубления местных признаков непроходимости или появления признаков эндотоксикоза вопрос о неотложном оперативном вмешательстве должен обсуждаться независимо от рентгенологических данных, характеризующих продвижение контраста по кишечнику;
3) если принимается решение о динамическом наблюдении за больным с контролем за пассажем по кишечнику контрастной массы (проба Шварца), то такое наблюдение следует сочетать с проведением лечебных мероприятий, направленных на устранение динамического компонента непроходимости. Эти мероприятия заключаются, главным образом, в применении антихолинергических, антихолинэстеразных и ганглиоблокирующих средств, а также проводниковой (паранефральной, сакроспинальной) или перидуральной блокады [1-3, 7, 9-12].
2. Колоноскопия (диагностическая и лечебная) является самым информативным методом диагностики заболеваний толстой кишки. В большинстве случаев она позволяет осмотреть толстую кишку на всем протяжении. Во время проведения колоноскопии визуально оценивается состояние слизистой оболочки толстой кишки, что позволяет на ранних стадиях выявить доброкачественные и злокачественные опухоли толстой кишки. Колоноскопия предоставляет возможность не только локализовать патологический процесс, но и выполнить интубацию суженной части кишки, разрешив явления острой непроходимости. Это позволяет выполнить оперативное вмешательство, как правило, по поводу онкологического заболевания в более благоприятных условиях [2, 4, 7, 14].
3. Ирригоскопия проводится при подозрении на непроходимость ободочной кишки. Под рентгенологическим контролем постепенно заполняют рентгеноконтрастной взвесью толстую кишку и производят обзорные и прицельные снимки всех ее отделов в разных положениях больного. На рентгенограммах можно обнаружить сужения и дефекты наполнения, обусловленные наличием опухоли в кишке, сужение дистального отдела сигмовидной кишки в виде «клюва» при ее заворотах, дефекты наполнения в виде «полулуния», «двузубца», «трезубца» при илеоцекальной инвагинации.
На следующем этапе, после удаления из толстой кишки рентгеноконтрастной взвеси, исследуют рельеф слизистой оболочки кишки.
На заключительном этапе ирригоскопии, особенно при подозрении на опухоль толстой кишки, исследование проводят при дозированном заполнении кишки воздухом, используя аппарат Боброва (двойное контрастирование).
4. Ультразвуковое исследование (УЗИ) широко применяется для оценки разных болезней органов брюшной полости, однако исследований, посвященных диагностике КН, не много. Это может быть связано с тем, что наличие большого количества газа в ЖКТ мешает успешному исследованию кишечника, а также с тем, что спайки в кишке (наиболее распространенная причина кишечной непроходимости) не визуализируются с помощью УЗИ.
Предпосылкой возможного использования ультразвукового (УЗ) метода для диагностики ОКН является избыточное скопление жидкого содержимого в просвете кишки, что позволяет при УЗ-сканировании ее визуализировать.
Избыточное скопление жидкости в кишечнике обусловлено как нарушением эвакуации и всасывания кишечного содержимого, так и пропотеванием жидкости в просвет кишки при развитии ее микроциркуляторных нарушений. В связи с этим жидкое содержимое в просвете кишки, определяемое при УЗИ, называют «симптомом секвестрации жидко
Кишечная непроходимость

Кишечная непроходимость — комплекс симптомов, формирующихся при полном или частичном нарушении трофики ЖКТ от ротового до анального отверстия. Синдром КН относится к тяжёлым состояниям. При отсутствии медицинской помощи пациент может столкнуться с интоксикацией организма каловыми массами, атрофией тканей пищеварительной системы, разрывами различных отделов кишечника, полиорганной недостаточностью.
Общие сведения
Рассматриваемый синдром приводит к полной или частичной блокировке просвета кишечника. Состояние угрожает жизни пациента и требует неотложной медицинской помощи. Непроходимость ЖКТ редко выступает самостоятельным заболеванием, в большинстве случаев становясь осложнением инфекционных патологий, системных расстройств, эндокринных нарушений и т. д.
Причины развития патологии
Разные формы КН обладают характерными симптомами, на основании которых происходит дифференциация патологии. Причинами наиболее распространённой формы непроходимости — рефлекторного спазма мускулатуры кишечника — становятся:
- ушибы и гематомы живота;
- острый панкреатит;
- нефролитиаз;
- желчная колика;
- отравление;
- базальная пневмония;
- переломы рёбер;
- острый инфаркт миокарда и т. д.
Сужение кишечного просвета при механической непроходимости обусловлено различными образованиями органического происхождения:
- каловыми массами;
- желчными камнями;
- безоарами;
- доброкачественными или злокачественными опухолями;
- затвердевшие каловые массы;
- желчные камни;
- безоары;
- клубок глистов;
- опухолевые образования, выпавшие в просвет кишечники или сдавившие его;
- посторонний предмет;
- сдавление трубки кишечника извне опухолевыми массами
У детей причины развития КН могут быть связаны с врождёнными аномалиями развития кишечной трубки. В группе риска состоят люди, долгое время принимавшие анальгетики и долго соблюдавшие вынужденный малоподвижный образ жизни.
Виды патологии
Существует несколько вариантов типологизации синдрома КН. Наиболее часто врачи выделяют следующие типы непроходимости:
- динамический;
- механический;
- сосудистый.
По локализации различают высокую и низкую тонкокишечную непроходимость (60-70% случаев), толстокишечную непроходимость (30-40% случаев). По степени сбоев проходимости пищеварительного тракта КН может быть полной или частичной; по клинике течения — острой, подострой и хронической. По времени формирования нарушений проходимости кишечника дифференцируют врождённую КН, связанную с внутриутробными пороками развития кишечной трубки, и приобретённую непроходимость, обусловленную другими причинами.
Симптомы кишечной непроходимости

Симптоматика патологии специфична:
- боли по типу схваток в области живота — совпадают с волной перестальтического напряжения, сопровождаются шоковой симптоматикой: учащённое сердцебиение, повышенное АД, бледность кожных покровов и холодный пот;
- синдром нарушения пассажа химуса — сопровождается задержкой дефекации и естественного выхода газов;
- вздутый живот — принято включать в классическую триаду симптомов ОКН;
- кровь в жидких каловых массах — результат внутренней геморрагии;
- множественные приступы рвоты — рвотные массы имеют цвет и запах желудочных масс, приступы не приносят облегчения;
- асимметрия формы живота;
- усиление петельной перестальтики.
Симптоматика полной непроходимости развивается резко, течение патологии острое. Симптомы частичной КН развиваются постепенно, стул и газы периодически отходят, что размывает клиническую картину и затрудняет постановку диагноза.
Стихание болей в животе через 12 часов после первых признаков закупорки кишечного тракта называется «мнимым улучшением», это результат некроза стенок кишечника, после которого наступает перитонит.
Локализация очага кишечной непроходимости имеет специфические признаки. При низкой КН происходит задержка стула и газов. При высокой КН стул может спорадически появляться, так как часть кишечника, расположенная ниже препятствия, опорожняется. При внедрении одной части кишки в другую наблюдаются кровянистые выделения из заднепроходного отверстия.
Диагностика патологии
Диагностические манипуляции выполняются гастроэнтерологом. Врач собирает анамнез и информацию о длительности симптомов непроходимости. Осмотр позволяет определить возможную причину возникновения КН (грыжу, послеоперационные рубцы) и специфические симптомы развивающейся патологии: вздувшийся асимметричный живот.
Для точной диагностики КН применяются инструментальные исследования:
- рентгенография нижнего отдела ЖКТ;
- КТ или МРТ.
- томография с контрастом (сульфатом бария);
- колоноскопия.
Данные, полученные врачами во время этих процедур, используются при выполнении хирургического вмешательства или разработке консервативной терапии.
Лечение кишечной непроходимости
Характер заболевания не позволяет ограничить лечебные мероприятия неинвазивными методами или консервативной терапией. Терапия обладает комплексным характером и зависит от ряда патогенетических, анатомических и клинических факторов. Медикаментозные назначения подбираются в соответствии с видом КН и тяжестью течения патологии. Препараты призваны подготовить пациента к оперативной стадии лечения и помочь ему восстановиться в послеоперационный период.
- внутривенное вливание жидкости, растворов с микроэлементами;
- спазмолитики или стимуляторы моторики.
- антибиотики.
Хирургическое вмешательство предполагает проведение полостной операции. Хирурги удаляют накопившиеся каловые массы, устраняют причину сужения просвета кишечника, удаляют поражённые некрозом участки органа.
Послеоперационная реабилитация
Протоколы послеоперационных мероприятий включают:
- внутривенное питание;
- обезболивающие препараты;
- ЛФК и физиотерапия после выписки пациента из отделения интенсивной терапии.
Рекомендована профилактика спаечного процесса (брюшной диализ, стимуляция моторики кишечника, антибактериальная терапия до и после операции, курс фибринолитических препаратов, применение антикоагулянтов).
Прогноз
Прогноз зависит от длительности заболевания и своевременности проведения операции, возраста пациента и сопутствующих заболеваний. При КН онкологической этиологии прогноз зависит от вида и распространённостью новообразования. Неблагоприятен прогноз для пожилых людей с хроническими заболеваниями сердечно-сосудистой системы.
Профилактика
Профилактика развития КН включает своевременный скрининг и удаление опухолей кишечника, предупреждение спаечной болезни, устранение глистной инвазии, правильное питание, избегание травм и т. д. При подозрении на кишечную непроходимость необходимо незамедлительное обращение к врачу.
Вопросы и ответы
— Какой врач диагностирует кишечную непроходимость?
— В зависимости от своевременности обращения, диагноз ставит гастроэнтеролог или хирург. В случаях симптоматической КН диагностировать непроходимость может онколог. Патология может быть обнаружена случайно при УЗИ или компьютерной томографии.
— В каких случаях пациента удаётся избежать операции на фоне КН?
— Консервативное лечение эффективно при выявлении расстройства на ранней стадии. Острое или осложнённое течение заболевание становится показанием для проведения операции.
— Какова продолжительность послеоперационной реабилитации?
— Реабилитационные процедуры могут продолжаться от 2 недель до полутора месяцев. Продолжительность этого периода определяется тяжестью КН и особенностями выполненного вмешательства.
Врожденная кишечная непроходимость
Врожденная непроходимость кишечника до настоящего времени остается главной причиной, требующей экстренного хирургического вмешательства в периоде новорожденности.
По уровню расположения препятствия различают непроходимость кишечника высокую и низкую, каждая из них имеет характерную клиническую картину.
Высокую непроходимость вызывает обструкция на уровне двенадцатиперстной и начальных отделов тощей кишки, низкую – на уровне дистальных отделов тощей, а так же подвздошной и толстой кишок.

Непроходимость двенадцатиперстной кишки
Учитывая анатомические особенности двенадцатиперстной кишки, непроходимость этого отдела может быть вызвана следующими причинами:
- стеноз
- атрезия
- сдавление просвета аномально расположенными сосудами (предуоденальной воротной веной, верхней брыжеечной артерией), эмбриональными тяжами брюшины (синдром Ледда) и кольцевидной поджелудочной железой.
Частота выявления в среднем составляет 1 на 5000-10000 живорожденных детей.
Особое внимание при атрезии 12-перстной кишки следует уделять пренатальному кариотипированию, так как хромосомные аномалии обнаруживаются в 30-67% случаев. Наиболее часто встречается синдром Дауна.
Симптомы высокой кишечной непроходимости обнаруживают уже в первые часы после рождения ребенка. Наиболее ранними и постоянными признаками являются повторные срыгивания и рвота, при этом в желудочном содержимом может обнаруживаться небольшая примесь желчи.
Вместе с желудочным содержимым ребенок теряет большое количество жидкости. При отсутствии терапии быстро наступает дегидратация. Ребенок становится вялым, адинамичным, происходит патологическая потеря веса.
При антенатальном ультразвуковом исследовании плода в верхнем отделе брюшной полости визуализируются расширенные и заполненные жидкостью желудок и двенадцатиперстная кишка – симптом «двойного пузыря» («double-bubble»), что в сочетании с многоводием позволяет установить диагноз уже с 20 недель беременности.
Для подтверждения диагноза после рождения ребенка применяют рентгенографическое исследование. С целью диагностики выполняют рентгенографию брюшной полости в вертикальном положении, на которой определяют два газовых пузыря и два уровня жидкости, соответствующие растянутым желудку и двенадцатиперстной кишке. У большинства пациентов этого исследования бывает достаточно для постановки диагноза.
При высокой кишечной непроходимости ребенку необходима операция, которую выполняют на 1-4 сутки жизни ребенка, в зависимости от тяжести состояния при рождении и сопутствующих заболеваний.
В нашем отделении операции по коррекции непроходимости двенадцатиперстной кишки проводятся исключительно лапароскопическим методом, в том числе и в случае, если ребенок рождается недоношенным и с малым весом. Выполняется обходной кишечный анастомоз по методике Кимура для восстановления проходимости двенадцатиперстной кишки.
Врожденные аномалии тонкой кишки в большинстве случаев представлены атрезиями на различных ее уровнях, наиболее часто встречается атрезия подвздошной кишки.
Большинство случаев атрезии тонкой кишки бывают спорадическими. В отличие от атрезии двенадцатиперстной кишки, при атрезии тонкой кишки хромосомные аберрации встречаются редко. От пренатального кариотипирования можно воздержаться в связи с низкой частотой хромосомных аномалий при этом пороке. При пролонгировании беременности и наличии выраженного многоводия для предупреждения преждевременных родов показан лечебный амниоцентез.
Поведение ребенка в первые часы после рождения не отличается от здорового. Основным признаком низкой кишечной непроходимости является отсутствие стула - мекония. При выполнении очистительной клизмы получают только слепки неокрашенной слизи.
К концу первых суток жизни состояние ребенка постепенно ухудшается, появляется беспокойство, болезненный крик. Быстро нарастают явления интоксикации – вялость, адинамия, серо-землистая окраска кожных покровов, нарушение микроциркуляции. Прогрессирует равномерное вздутие живота, петли кишечника контурируют через переднюю брюшную стенку. Отмечается рвота застойным кишечным содержимым. Течение заболевания может осложниться перфорацией петли кишечника и каловым перитонитом, в этом случае состояние ребенка резко ухудшается, появляются признаки шока.
Обструкция тонкой кишки антенатально у плода визуализируется в виде множественных расширенных петель кишечника, при этом количество петель отражает уровень непроходимости. Увеличение количества вод и множественные дилатированные петли тонкой кишки, особенно с усиленной перистальтикой и плавающими частицами мекония в просвете кишки, позволяет заподозрить атрезию тонкого кишечника.
Прямая обзорная рентгенография брюшной полости в вертикальном положении демонстрирует значительное расширение петель кишечника и уровни жидкости в них. Чем больше петель визуализируется, тем ниже располагается препятствие.
Новорожденный с признаками низкой кишечной непроходимости нуждается в экстренном хирургическом лечении. Предоперационная подготовка может проходить в течение 6-24 ч, что позволяет дополнительно обследовать ребенка и устранить водно-электролитные нарушения. Продливать предоперационную подготовку не следует в связи с высоким риском развития осложнений (перфорация кишечника и перитонит). Целью хирургического вмешательства является восстановление целостности кишечника при возможном сохранении максимальной его длины.
В нашем отделении оперативное лечение проводится не позднее, чем 1-е сутки жизни. При этом приоритетным является максимальное сохранение длины имеющейся кишки и наложение одномоментного прямого адаптрированного кишечного анастомоза, что избавляет ребенка от необходимости повторных операций и носительства кишечных стом.
В ФГБУ «Национальный медицинский исследовательский центр акушерства, гинекологии и перинатологии имени академика В.И. Кулакова» Минздрава России Вы получаете уникальную возможность получить БЕСПЛАТНО оперативное стационарное лечение по квотам на высоко-технологическую медицинскую помощь (ВМП по ОМС).
Читайте также:
